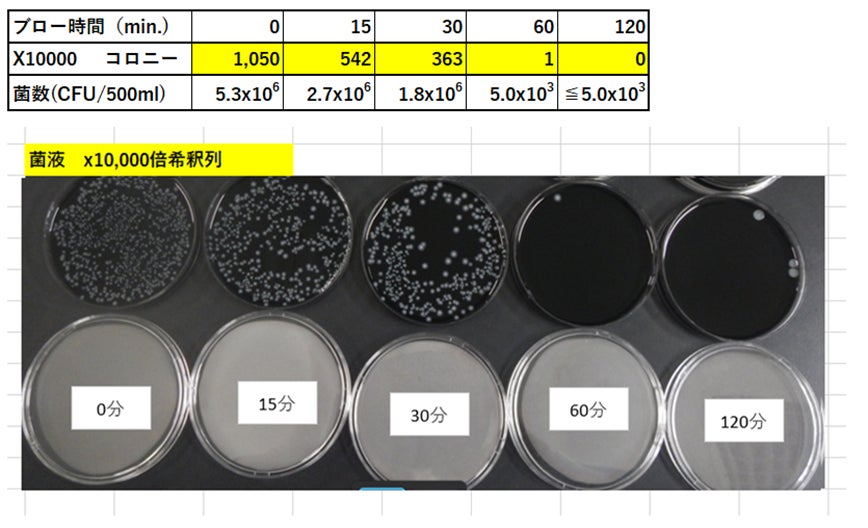

コールドプラズマがレジオネラ菌に効果を発揮
レジオネラ菌の除菌・抑制に新たな技術を開発
同社は、コールドプラズマ技術(特許出願中9件)を応用した機器(「プラズマエアー(以下、CHEFER AIR)」、およびROSを水などの液相に混在した「プラズマウォーター(以下、CHEFER WATER)」)のプロトタイプ機を製造しています。
レジオネラ菌の対策では一般的に塩素系の薬剤が使用されますが、今回の実験では塩素をはじめ化学薬品などは一切使用せず、ROSのみを用いて消毒効果を検証しました。また、レジオネラ菌に対しては60℃以上の温水が必要とされるところ、今回使用したROSを混在させた水は15℃~20℃程度の常温で効果が認められました。
検証結果は、ROSを含む CHEFER WATERを使い、30分で0.346%、60分で検出限界以下、120分でほぼ0%にまでレジオネラ菌を除去するエビデンスを取得しました。
(詳細は下記参照)
株式会社カーボントレードは、このCHEFER WATERを生成・供給する製品開発を進め、温泉や施設の入浴設備、プール設備の清掃や除菌、消毒など、衛生管理業務の効率化と、レジオネラ菌増殖による経営・営業リスクの低減につながるソリューションを提供してまいります。
【開発の背景】
株式会社カーボントレードでは、従前よりコールドプラズマを使用し、空気だけを原材料にして生成されるCHEFER AIRの開発と製品化に取り組んでおり、2023年7月より空間におけるウイルスや浮遊菌、付着菌を直接攻撃し撃退するCHEFER AIR(型式CT-21,CT-11)の販売を開始しています。製品情報:https://carbontrade.co.jp/product/chefer/
更にこのCHEFER AIRを水などの液相に混在させ、液体で利用する方式でウイルスや細菌類に対して不活化効果・除菌効果を持つCHEFER WATERの開発を進めており、この中でレジオネラ菌に対する殺菌・漸減効果を確認しエビデンスを取得しました。
【レジオネラ菌の殺菌・漸減に対する試験結果・エビデンス】
レジオネラ菌:分離株20190725
【CHEFER AIR・WATERの概要】
株式会社カーボントレードが持つコールドプラズマ技術は、50W程度以下の低電力でプラズマを発生させることができ、また、従来「点」レベルでしか発生させることができなかったプラズマを、「面」でかつ「自由な形状」で発生させることができます。

この技術によってコールドプラズマによる処理効率が飛躍的に向上し、空気を原材料としROSが混在したCHEFER AIRの大量生成を実現しています。
CHEFER WATERはこのCHEFER AIRを水に混在させるもので、CHEFER AIR・WATERともに、ウイルスや細菌類・カビ類の不活化や除去、除菌・消毒を目的とした用途に幅広くご利用いただけます。
【今後の展開】
株式会社カーボントレードでは、公益社団法人 全国水利用設備環境衛生協会(東京都台東区、会長:大熊 久之)と連携し、温泉や入浴施設、プール施設などの清掃や除菌、消毒などを目的としたCHEFER AIR、CHEFER WATERのアプリケーションを開発し、衛生管理業務に係わる各事業者様や企業様との協力関係のもと、レジオネラ菌対策や水回り設備の衛生管理に係わる解決策を提供していきます。
【お問合わせ】
株式会社カーボントレード
〒107-0052 東京都港区赤坂3-21-20 赤坂ロングビーチビル4F
TEL 03-5797-7768 FAX 03-5797-7769
担当:日下 kusaka@carbontrade.co.jp
ホームページ https://carbontrade.co.jp/
すべての画像
